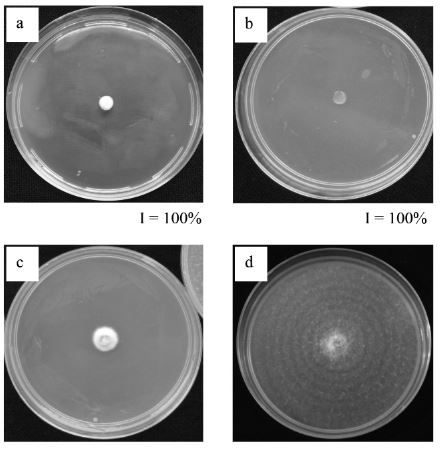
Efecto de aceites esenciales sobre el crecimiento micelial in vitro de Fusarium oxysporum a los 10 días de edad. a: clavo (S. aromaticum) 100μl·l-1, b: tomillo (T. vulgaris) 200μl·l-1, c: orégano (O. vulgare) 400μl·l-1, d: testigo. I: inhibición del crecimiento micelial de F. oxysporum expresado en porcentaje.

ETIOLOGÍA DE LA MUERTE PREMATURA DEL CILANTRO (Coriandrum sativum L.) EN OCOTLÁN DE MORELOS, OAXACA, MÉXICO Y EFECTO DE ACEITES ESENCIALES in vitro SOBRE EL PATÓGENO
ETIOLOGY OF PREMATURE PLANT DEATH IN CORIANDER (Coriandrum sativum L.) IN OCOTLÁN DE MORELOS, OAXACA, MEXICO AND EFFECT OF ESSENTIAL OILS in vitro ON THE PATHOGEN
ETIOLOGIA DA MORTE PREMATURA DO COENTRO (Coriandrum sativum L.) EM OCOTLÁN DE MORELOS, OAXACA, MÉXICO, E EFEITO DE ÓLEOS ESSENCIAIS IN VITRO SOBRE O PATÓGENO
ETIOLOGÍA DE LA MUERTE PREMATURA DEL CILANTRO (Coriandrum sativum L.) EN OCOTLÁN DE MORELOS, OAXACA, MÉXICO Y EFECTO DE ACEITES ESENCIALES in vitro SOBRE EL PATÓGENO
Interciencia, vol. 42, núm. 9, pp. 591-596, 2017
Asociación Interciencia
Recepción: 01 Junio 2016
Corregido: 17 Agosto 2017
Aprobación: 17 Agosto 2017
Resumen: Se determinó la etiología de la muerte prematura del cilantro (Coriandrum sativum L.) en Oaxaca, México y se evaluó el efecto de los aceites esenciales de Syzygium aromaticum, Thymus vulgaris, Origanum vulgare, Cymbopogon citratus, Bursera linanoe, Laurus nobilis, Larrea tridentata . Mentha pulegium, en las dosis de 50, 100, 200 y 400μl·l-1 de medio de cultivo papa-dextrosa-agar, sobre la inhibición (%) del crecimiento micelial in vitro del patógeno. De raíces de cilantro sintomático se obtuvieron aislados fungosos cuya patogenicidad se verificó en plantas sanas de cilantro. El patógeno se caracterizó morfométrica y molecularmente, y se identificó como Fusarium oxysporum. El hongo causó constricción en la raíz primaria, pudrición de raíces secundarias, marchitez y muerte prematura en 100% de las plantas después de 20 días de ser inoculadas. Los aceites de S. aromaticum . T. vulgaris, en dosis de 100 y 200μl·l-1, respectivamente, inhibieron en 100% el crecimiento micelial de F. oxysporum. El aceite de O. vulgare, en dosis de 400μl·l-1, lo inhibió en 96%. Los aceites restantes, a partir de 400μl·l-1 inhibieron el crecimiento fungoso entre 12 y 46%.
Palabras clave: Aceites Esenciales, Cilantro, Coriandrum sativum . Fusarium oxysporum . Origanum vulgare , Patogenicidad, Syzygium aromaticum . Thymus vulgaris .
Abstract: The etiology of premature death of the coriander (Coriandrum sativum L.) plant in Oaxaca, Mexico was determined and the effect essential oils ofSyzygium aromaticum, Thymus vulgaris, Origanum vulgare, Cymbopogon citratus, Bursera linanoe, Laurus nobilis, Larrea tridentata and Mentha pulegium was assessed, in dosages of 50, 100, 200 and 400μl·l-1 of potato-dextrose agar culture medium, on the inhibition (%) of in vitro mycelial growth of the pathogen. Fungal isolates were obtained from the roots of symptomatic coriander plants and their pathogenicity was verified in non-symptomatic coriander plants. Morphometric and molecular characterization of the pathogen was done and was identified as Fusarium oxysporum. The fungi caused constriction of the primary roots, rot of secondary roots, wilt and premature death of 100% of inoculated plants after 20 days. S. aromaticum and T. vulgaris oils in 100 and 200μl·l-1 dosages, respectively, inhibited 100% of F. oxysporum mycelial growth. O. vulgare oils at a dose of 400μl·l-1 showed 96% growth inhibition. For the other oils, 400μl·l-1 doses inhibited between 12 and 46% of fungal growth.
Resumo: Determinou-se a etiologia da morte prematura do coentro (Coriandrum sativum L.) em Oaxaca, México e se avaliou o efeito dos óleos essenciais de Syzygium aromaticum, Thymus vulgaris, Origanum vulgare, Cymbopogon citratus, Bursera linanoe, Laurus nobilis, Larrea tridentata . Mentha pulegium, nas doses de 50, 100, 200 e 400μl·l-1 do meio de cultivo Batata, Dextrose, Agar, sobre a inibição (%) do crescimento micelial in vitro do patógeno. De raízes de coentro sintomático se obtiveram isolados de fungos cuja patogenicidade se verificou em plantas sadias de coentro. O patógeno se caracterizou morfométrica e molecularmente, e se identificou como Fusarium oxysporum. O fungo causou constrição na raiz primária, apodrecimento de raízes secundárias, murchamento e morte prematura em 100% das plantas após 20 dias de serem inoculadas. Os óleos de S. aromaticum e T. vulgaris, em doses de 100 e 200μl·l-1, respectivamente, inibiram em 100% o crescimento micelial de F. oxysporum. O óleo deO. vulgare, em doses de 400μl·l-1, o inibiu em 96%. Os óleos restantes, a partir de 400μl·l-1 inibiram o crescimento de fungos entre 12 e 46%.
Introducción
El cilantro (Coriandrum sativum L.), originario de países del Mediterráneo, se cultiva en regiones de clima templado de todo el mundo. Tiene importancia económica en la industria farmacéutica, cosmética y gastronómica, y presenta un alto valor cultural en la medicina tradicional de muchos países (Coşkuner y Karababa, 2007; Mildner et al., 2009; Asgarpanah y Kazemivash, 2012). El cilantro se cultiva especialmente para la producción de semillas, de las que se extrae un aceite esencial compuesto principalmente de linalol (Msaada et al., 2007) cuya importancia radica en que es un agente fitoterapeútico con actividad antioxidante; antibacterial, antifúngica, antidiabética, anticancerígena, antireumática, etc. (Wangens-teen et al., 2004; Zoubiri y Baaliouamer, 2010; Silva et al., 2011). México produce 46000t de cilantro al año, es el cuarto productor a nivel mundial y la producción se destina principalmente al consumo en fresco. El estado de Oaxaca participa con el 20% de la producción nacional (SAGARPA, 2015). En la localidad de Ocotlán de Morelos, Oaxaca, la produc-ción de cilantro es primordial para la economía del 40% de las familias; sin embargo, una de las limitantes de la producción son los problemas fitosanitarios existentes. En 2012, en plantíos comerciales de cilantro, se observaron plantas de 30 días de edad con síntomas de marchitez y muer te prematura. En las raíces de las plantas enfermas se observó constricción, agrietamiento y pudrición del cuello de la raíz primaria, con áreas necróticas en el tejido interno; las raíces secundarias presentaron pudrición. En México, hasta el momento no se había precisado el agente causal de la enfermedad. En el escenario mundial, estudios previos indicaron que la marchitez y muerte de las plantas de cilantro puede ser causada por Fusarium oxysporum en la India (Srivastava, 1972), Argentina (Gaetán et al., 1999) y EEU U (Koike y Gordon, 2005) o por Pythium ultimum en Italia (Garibaldi et al., 2010). Síntomas similares han sido repor tados como inducidos por bacterias tales como Erwinia carotovora en Brasil (Romeiro, 1994), Pseudomonas syringae pv. coriandricola en Alemania (Toben y Rudolph, 1996) y Xanthomonas campestris en Venezuela (Guevara y Maselli, 2005).
Las enfermedades del cilantro en Oaxaca se controlan con fungicidas selectivos, que si bien muestran eficacia contra los fitopatógenos, también tienen efectos adversos al medio ambiente y a la salud pública, ya que pueden inducir problemas carcinogénicos, teratogénicos y/o de toxicidad residual en el ser humano (Xiong et al., 2014), incrementar los costos de producción y resistencia inducida en los patógenos (Al- Haq et al., 2002). Por esta razón, es importante encontrar alternativas sustentables, atóxicas, inocuas, biodegradables y de baja o nula residualidad en productos agrícolas para el control de las enfermedades. En años recientes, las propiedades biológicas de los extractos de plantas se ha puesto en auge y diversos estudios han sugerido la posibilidad de usar los aceites esenciales o mo-léculas específicas en la ciencia de la fitopatología para el control de patógenos (Lo Cantore et al., 2004).
Los aceites esenciales vegetales han mostrado propiedades antibacterianas, antimicóticas, antiparasitarias, insecticidas y nematicidas (Bur t, 2004; Ponce et al., 2004; Kim et al., 2008). El aceite esencial de S. aromaticum inhibe el crecimiento micelial de Asper-gillus niger, Geotrichum candidum (Verma et al., 2011), Fusarium oxysporum f. sp. lycopersici, Rhizoctonia solani, Verticilllium dahliae (López et al., 2005) y Colle-totrichum sp. (Ranasinghe et al., 2002). El aceite de T. vulgaris impide el crecimiento de Botryodiplodia theobro-mae (Tripathi y Shukla, 2009), Colletotrichum acutatum (Alzate et al., 2009) y Fusarium spp. (Bar rera y García, 2008). El aceite esencial de O. vulgare controla el crecimiento de Botrytis cinerea . Fusarium sp. (Daferera et al., 2003).
En este contexto, el uso de aceites esenciales o moléculas específicas puede ser una alternativa viable y prometedora para el manejo de fitopatógenos. Los objetivos de este estudio fueron determinar la etiología de la muerte prematura del cilantro (Coriandrum sativum L.) en Oaxaca, México y evaluar el efecto de cuatro dosis (50, 100, 200 y 400μl·l-1) de los aceites esenciales de Bursera linanoe, Cymbopogon citratus, Larrea tridentata, Laurus nobilis, Mentha pulegium, Origanum vulgare, Syzygium aromaticum . Thymus vulgaris sobre la inhibición (%) del crecimiento micelial in vitro del patógeno.
Materiales y Métodos
Área de estudio
El estudio se realizó en Ocotlán de Morelos (16º48’N, 96º40’O, a 1,523 msnm), localidad ubicada en la región de los Valles Centrales del estado de Oaxaca, México.
Material vegetal
En campo se recolectaron 250 muestras de tejido interno de la raíz primaria de plantas de cilantro de 30 días de edad con síntomas de marchitez y muerte prematura. La recolección se llevó a cabo en un área de 0,5ha mediante un patrón de muestreo en ‘W’.
Aislamiento y purificación de hongos
Las muestras fueron lavadas con agua destilada estéril y desinfestadas con hipoclorito de sodio a 2,0% durante 5min. Se sembraron en medio de cultivo papa-dextrosa-agar (PDA; Bioxon® B ecton D ickinson d e México) con ácido láctico e incubaron a 22 ±3ºC con luz blanca durante 8 días. Las colonias desarrolladas se purificaron mediante la técnica de cultivo monospórico y se preservaron en tubos con PDA cubiertos con aceite mineral estéril.
Pruebas de patogenicidadPruebas de patogenicidad
El inóculo de los hongos experimentales se incrementó en sustrato estéril compuesto de 70% de suelo agrícola, 29% de arena y 1% harina de maíz. En 1,0kg de sustrato se colocaron 10 discos de 0,7cm de diámetro de medio de cultivo PDA con crecimiento micelial de 10 días de edad; el sustrato se incubó durante 45 días en oscuridad y humedad constante a una temperatura de 22 ±3ºC. La patogenicidad de los hongos se verificó en plantas sanas de cilantro de 30 días de edad cultivadas individualmente en bolsas de polietileno con 500g de suelo estéril. Alrededor de sistema radicular de cada planta se colocó 100g de inóculo; las plantas se mantuvieron a cielo abierto a temperatura ambiente (22 ±2ºC) y humedad constante durante 25 días.
Las plantas de cilantro inoculadas con el aislado H1 se observaron marchitas en su totalidad a los 15 días después de la inoculación (ddi) y a 20 ddi la incidencia de plantas muertas fue de 100% (Figura 1). En la raíz principal hubo agrietamiento con tejido interno necrótico de donde se re-aisló la cepa H1. En el tratamiento donde las plantas fueron inoculadas con los aislados H2 y H3 la incidencia de plantas muertas, en ambos casos, fue de 20% a 20 ddi; sin embargo, no se observaron daños en la raíz principal. Las plantas inoculadas con las cepas H4, H5 y H6 no mostraron síntomas.
Figura 1. Pruebas de patogenicidad. a: plantas de cilantro inoculadas con Fusarium oxysporum a 20 ddi; la incidencia de plantas con muerte prematura fue de 100%; b: plantas testigo.
Tratamientos
Cada hongo evaluado se consideró un tratamiento, cada uno con 10 repeticiones. La unidad experimental fue una planta de cilantro.
Incidencia de la enfermedad
La incidencia de la enfermedad por tratamiento se estimó con la ecuación: Ii= (Σni/ Ni) ×100; donde Ii: incidencia (%) de plantas enfermas en el momento i; ni: número de plantas enfermas en el momento i; Ni: población total de plantas inoculadas en cada tratamiento. La evaluación se realizó a los 15 y 20 días después de efectuada.
Caracterización morfométrica y molecular del patógeno
La caracterización morfométrica se realizó a partir de colonias puras cultivadas en PDA 2,0% a 25ºC y luz blanca constante por 10 días; siguiendo las claves para género de Barnett y Hunter (2006). La especie del patógeno se determinó de acuerdo a las claves de Nelson et al. (1983), Burgess et al. (1994) y Leslie y Summerell (2006). Se determinó el color de la colonia, las dimensiones de 100 macroconidios, 100 microconidios y 100 fiálides. La caracterización molecular se realizó con la metodología propuesta por Ahrens y Seemüller (1992). La amplificación de las regiones ITS1 e ITS2 de los genes ribosomales se hizo por PCR con los iniciadores universales ITS5 (GGA AGT AAA AGT CGT AAC AAG G) e ITS4 (TCC TCC GCT TAT TGA TAT GC) (White et al., 1990) y se alinearon con la base de datos del banco de genes del National Center for Biotechno-logy Information (NCBI; www. ncbi.nlm.nih. gov). Las secuencias con el valor más alto de identidad se compararon con las de este estudio.
Efecto de aceites esenciales en la inhibición del crecimiento del patógenoEfecto de aceites esenciales en la inhibición del crecimiento del patógeno
Se evaluaron cuatro dosis (50, 100, 200 y 400μl·l-1) de cada uno de los siguientes aceites esenciales: clavo (S. aromaticum L.), tomillo (T. vulgaris L.), orégano (O. vulgare L.), té limón (C. citratus DC. Stapf.), linaloe (B. linanoe (La Llave) Rze-dowski, Calderón y Medina), Laurel (L. nobilis L.), gobernadora (L. tridentata (Sessé & Moc. ex DC.) Coville) y poleo (M. pulegium L.). Las plantas se secaron en la sombra (22 ±2ºC) durante 20 días y se molieron. Los aceites se extrajeron por la técnica de hidrodestilación asistido por microondas en un aparato Clevenger. La fuente de calentamiento fue un horno de microondas modificado (Sam-sung MW1235WB de 1,1pies3, 2450MHz, 1000W). El aceite esencial resultante se secó con sulfato de sodio anhidro y se almacenó en frascos color ámbar a 4ºC (Granados et al., 2014).
Cada dosis de aceite se mezcló en 1 litro de medio de cultivo PDA a 30ºC y se vació en cajas de Petri de 8,5cm de diámetro. Sobre el medio de cultivo se colocó un disco micelial de 0,7cm de diámetro y 10 días de edad. Las cajas se incubaron a 22 ±2ºC durante 10 días con luz natural.
La efectividad de los aceites se estimó mediante el parámetro porcentaje de inhibición del crecimiento micelial del patógeno in vitro con la fórmula I= ((C-T)/C)x100, donde I: inhibición del crecimiento micelial expresada en porcentaje, C: crecimiento micelial (diámetro en cm) del testigo, y T: crecimiento micelial (diámetro en cm) del hongo tratado con aceites esenciales (Vincent, 1947). Las mediciones se realizaron cada 24h durante 10 días.
El aceite esencial de S. aromaticum . T. vulgaris, a partir de una dosis de 100 y 200μl·l-1, respectivamente, inhibieron en 100% el crecimiento micelial de F. oxysporum in vitro, mientras que el aceite de O. vulgare, a una dosis de 400μl·l-1 lo inhibió en 96% (Figura 3). Los aceites esenciales de C. citratus, B. linanoe, L. nobilis, L. tridentata . M. pulegium, a partir de la dosis de 400μl·l-1, inhibieron el crecimiento micelial en 46, 31, 28, 25 y 12%, respectivamente. Los porcentajes de inhibición están referidos al testigo absoluto. En todos los casos, el testigo positivo (oxicloruro de cobre) inhibió en 100% el crecimiento de F. oxysporum. La efectividad de los aceites, estimada mediante el parámetro porcentaje de inhibición del crecimiento micelial in vitro del patógeno, se indica en la Tabla II.
Los aceites esenciales de especies vegetales contienen moléculas específicas que confieren propiedades antibacterianas y antifúngicas (Burt, 2004; López et al., 2005). Moléculas con este potencial son el eugenol y acetato de eugenilo que se encuentran en el aceite de S. Aromaticum, mientras que el timol, carvacrol, α-terpineno y p-cymeno son moléculas del aceite de T. vulgaris . O. vulgare (McGimpsey et al., 1994;Prudent et al., 1995; Sivro-poulou et al., 1996; Russo et al., 1998; Cosentino et al., 1999; Daferera et al., 2000). Se ha referido que el aceite de S. aromaticum tiene capacidad para inhibir el crecimiento de A. niger, G. candidum (Verma et al., 2011), F. oxysporum f. sp. lycopersici, R. solani . V. dahliae (López et al., 2005), mientras que el aceite de T. vulgaris . O. vulgare inhiben el crecimiento de F. oxysporum, B. theobromae (Tripathi y Shukla, 2009), C. acutatum (Alzate et al., 2009) y Fusarium spp. (Barrera y García, 2008).
Una de las características importantes de los aceites esenciales es su hidrofobicidad. En bacterias, esta propiedad permite que las moléculas de los aceites interactúen con los lípidos de la membrana y mitocondrias celulares, confiriendo permeabilidad a la célula, lo que provoca un flujo continuo de iones intracelulares, alteración del citoplasma y coagulación del contenido celular (Sikkema et al., 1995). El timol, carvacrol y eugenol provocan permeabilidad, desintegración de la membrana celular e inhibición de producción de enzimas (Thoroski et al., 1988; Lambert et al., 2001).
De acuerdo a los resultados del presente estudio, la inhibición del crecimiento micelial de Fusarium oxysporum, agente causal de la muerte prematura del cilantro en Oaxaca, México, se debió probablemente a la presencia de moléculas contenidas en aceites esenciales de S. aromaticum (eugenol y acetato de eugenilo) T. vulgaris . O. vulgare (timol, carvacrol, α-terpineno y p-cymeno). Estos resultados fueron satisfactorios en condiciones in vitro; ahora el reto será diseñar estrategias para que estos aceites interactúen con el inóculo del patógeno que se encuentra de forma sistémica dentro de las plantas de cilantro sintomáticas.
Diseño experimental
Se establecieron 32 tratamientos resultantes de la interacción de ocho aceites esenciales y cuatro dosis. Se incluyó un testigo absoluto y un testigo positivo donde el fitopatógeno se sembró en PDA sin aceite esencial y en PDA con 0,3g·l-1 oxicloruro de cobre, respectivamente. La efectividad de los aceites se evaluó con un diseño completamente al azar con arreglo factorial AΧB; donde el factor A fueron los aceites esenciales (ocho) y el factor B fueron las dosis (cuatro) y dos testigos (testigo absoluto y testigo positivo). Se utilizó la prueba de Tukey (SAS, 2002) para la comparación de medias entre tratamientos (α= 0,05).
Resultados y Discusión
Hongos aislados
A partir de 250 muestras de tejido de raíces de plantas de cilantro sintomáticas se obtuvieron seis aislados fungosos diferentes que fueron etiqueta dos como H1, H2, H3, H4, H5 y H6. El aislado identificado como H1 se obtuvo con mayor frecuencia (Tabla I).

Pruebas de patogenicidad
Las plantas de cilantro inoculadas con el aislado H1 se observaron marchitas en su totalidad a los 15 días después de la inoculación (ddi) y a 20 ddi la incidencia de plantas muertas fue de 100% (Figura 1). En la raíz principal hubo agrietamiento con tejido interno necrótico de donde se re-aisló la cepa H1. En el tratamiento donde las plantas fueron inoculadas con los aislados H2 y H3 la incidencia de plantas muertas, en ambos casos, fue de 20% a 20 ddi; sin embargo, no se observaron daños en la raíz principal. Las plantas inoculadas con las cepas H4, H5 y H6 no mostraron síntomas.

Caracterización morfométrica
Las colonias identificadas como H1, H2 y H3 en medio de cultivo PDA produjeron micelios de color blanco con una pigmentación rosa-violeta en la parte inferior del cultivo a los 15 días de edad (Figura 2a); microconidios amerosporas, ovales, hialinos, de 6,6-12,2 × 2,9-5,6μm; originándose en cabezas sobre monofiálides hialinas de 4,1-7,5μm de longitud; y macroconidios fragmosporas, hialinos, en forma de media luna, con cinco septos en promedio, de 14,7-23,8 × 3,7-9,6μm, célula apical aguda y célula basal en forma de pie (Figura 2b). Las características morfométricas de estos aislamientos coinciden con las reportadas por Nelson et al. (1983), Burgess et al. (1994), Leslie y Summerell (2006) para F. oxysporum.

Caracterización molecular
La caracterización molecular se realizó solamente para la colonia identificada como H1 debido a los resultados obtenidos en las pruebas de patogenicidad. La secuencia genética del fragmento de ADN de la cepa H1 amplificado con los iniciadores universales ITS4 e ITS5 se homologó en 100% con F. oxysporum depositado en el banco de genes del NCBI con número de acceso HQ649816.1.
En este estudio se determinó que F. oxysporum es el agente causal de la marchitez y muerte prematura del cilantro en el estado de Oaxaca, México. En estudios previos, Srivastava (1972), Gaetán et al. (1999) y Koike y Gordon (2005) consignaron a este mismo hongo como el responsable de inducir marchitez y muerte prematura de las plantas de cilantro en la India, Argentina y EEUU, respectivamente. Se reportó que en plantíos de cilantro se observaron áreas de ~1m2 con plantas marchitas con poco crecimiento, las raíces presentaron pudrición de la corona con desprendimiento de corteza; los tallos exhibieron áreas descoloridas con tonalidad rojiza a café, con secamiento paulatino del follaje; finalmente las plantas murieron. Garibaldi et al. (2010) indicó que en Italia la enfermedad es causada por Pythium ultimum con sintomatología similar a la inducida por F. oxysporum.
Efecto de aceites esenciales en la inhibición del crecimiento del patógeno
El aceite esencial de S. aromaticum y T. vulgaris, a partir de una dosis de 100 y 200μl·l-1, respectivamente, inhibieron en 100% el crecimiento micelial de F. oxysporum in vitro, mientras que el aceite de O. vulgare, a una dosis de 400μl·l-1 lo inhibió en 96% (Figura 3). Los aceites esenciales de C. citratus, B. linanoe, L. nobilis, L. tridentata y M. pulegium, a partir de la dosis de 400μl·l-1, inhibieron el crecimiento micelial en 46, 31, 28, 25 y 12%, respectivamente. Los porcentajes de inhibición están referidos al testigo absoluto. En todos los casos, el testigo positivo (oxicloruro de cobre) inhibió en 100% el crecimiento de F. oxysporum. La efectividad de los aceites, estimada mediante el parámetro porcentaje de inhibición del crecimiento micelial in vitro del patógeno, se indica en la Tabla II.
Los aceites esenciales de especies vegetales contienen moléculas específicas que confieren propiedades antibacterianas y antifúngicas (Burt, 2004; López et al., 2005). Moléculas con este potencial son el eugenol y acetato de eugenilo que se encuentran en el aceite de S. Aromaticum, mientras que el timol, carvacrol, α-terpineno y p-cymeno son moléculas del aceite de T. vulgaris y O. vulgare (McGimpsey et al., 1994; Prudent et al., 1995; Sivro-poulou et al., 1996; Russo et al., 1998; Cosentino et al., 1999; Daferera et al., 2000). Se ha referido que el aceite de S. aromaticum tiene capacidad para inhibir el crecimiento de A. niger, G. candidum (Verma et al., 2011), F. oxysporum f. sp. lycopersici, R. solani y V. dahliae (López et al., 2005), mientras que el aceite de T. vulgaris y O. vulgare inhiben el crecimiento de F. oxysporum, B. theobromae (Tripathi y Shukla, 2009), C. acutatum (Alzate et al., 2009) y Fusarium spp. (Barrera y García, 2008).
Una de las características importantes de los aceites esenciales es su hidrofobicidad. En bacterias, esta propiedad permite que las moléculas de los aceites interactúen con los lípidos de la membrana y mitocondrias celulares, confiriendo permeabilidad a la célula, lo que provoca un flujo continuo de iones intracelulares, alteración del citoplasma y coagulación del contenido celular (Sikkema et al., 1995). El timol, carvacrol y eugenol provocan permeabilidad, desintegración de la membrana celular e inhibición de producción de enzimas (Thoroski et al., 1988; Lambert et al., 2001).
De acuerdo a los resultados del presente estudio, la inhibición del crecimiento micelial de Fusarium oxysporum, agente causal de la muerte prematura del cilantro en Oaxaca, México, se debió probablemente a la presencia de moléculas contenidas en aceites esenciales de S. aromaticum (eugenol y acetato de eugenilo) T. vulgaris y O. vulgare (timol, carvacrol, α-terpineno y p-cymeno). Estos resultados fueron satisfactorios en condiciones in vitro; ahora el reto será diseñar estrategias para que estos aceites interactúen con el inóculo del patógeno que se encuentra de forma sistémica dentro de las plantas de cilantro sintomáticas.

* Ta: testigo absoluto (medio de cultivo PDA sin aceite o fungicida comercial).
** Tp: testigo positivo (medio de cultivo PDA mezclado con oxicloruro de cobre a razón de 0,3g·l-1). Valores con la misma letra son estadísticamente iguales (Tukey, P<0,05).
Conclusiones
Se determinó que Fusarium oxysporum es el agente causal de la marchitez y muerte prematura del cilantro (Corian-drum sativum L.) en el estado de Oaxaca, México. Se consignó que los aceites esenciales de S. aromaticum . T. vulgaris inhibieron en 100% el crecimiento micelial de F. oxysporum en condiciones in vitro a partir de una dosis de 100 y 200μl·l-1, respectivamente. Mientras que O. vulgare lo inhibió en 96% a partir de una dosis de 400 μl/l. Los aceites esenciales de C. citratus, B. linanoe, L. nobilis, L. tridentata . M. pulegium, a partir de la dosis de 400μl·l-1, inhibieron el crecimiento micelial en 46, 31, 28, 25 y 12%, respectivamente.
REFERENCIAS
Ahrens U, Seemüller E (1992) Detection of DNA of plant pathogenic mycoplasmalike organisms by polymerase chain reaction that amplifies sequence of the 16SrRNA gene. Phyto-pathology 82: 828-832.
Alzate ODA, Mier MGI, Afanador KL, Durango RDL, García PCM (2009) Evaluación de la fitotoxicidad y la actividad antifúngica contra Colletotrichum acutatum de los aceites esenciales de tomillo (Thymus vulgaris), limoncillo (Cymbopogon citratus), y sus componentes mayoritarios. Vitae 16: 116-125.
Al-Haq MI, Seo Y, Oshita S, Kawagoe Y (2002) Disinfection effects of electrolyzed oxidizing water on suppressing fruit rot of pear caused by Botryosphaeria berengeriana. Food Res. Int. 35: 657-664.
Asgarpanah J, Kazemivash N (2012) Phytochemistry, pharmacology and medicinal properties of Coriandrum sativum L. Afr. J. Pharm. Pharmacol. 6: 2340-2345.
Barnett HL, Hunter BB (2006) Illustrated Genera of Imperfect Fungi. 4a ed. The American Phytopathological Society. St. Paul, MN, EEUU. 218 pp.
Barrera NLL, García BLJ (2008) Actividad antifúngica de aceites esenciales y sus compuestos sobre el crecimiento de Fusarium sp. aislado de papaya (Carica papaya). UDO Agríc. 8: 33-41.
Burgess LW, Summerell BA, Bullock S, Gott KP, Backhouse D (1994) Laboratory Manual for Fusarium Research. 3a ed. Sydney University. Sydney, Australia. 133 pp.
Burt S (2004) Essential oils: their antibacterial properties and potential applications in foods - a review. Int. J. Food Microbiol. 94: 223-253.
Cosentino S, Tuberoso CIG, Pisano B, Satta M, Mascia V, Arzedi E, Palmas F (1999) In vitro antimicrobial activity and chemical composition of Sardinian Thymus essential oils. Lett. Appl. Microbiol. 29: 130-135.
Coşkuner Y, Karababa E (2007) Physical properties of coriander seeds (Coriandrum sativum L.). J. Food Eng. 80: 408-416.
Daferera DJ, Ziogas BN, Polissiou MG (2000) GC-MS analysis of essential oils from some Greek aromatic plants and their fun-gi toxicity on Penicillium digitatum. J. Agric. Food Chem. 48: 2576-2581.
Daferera DJ, Ziogasb BN, Polissiou MG (2003) The effectiveness of plant essential oils on the growth of Botritis cinerea, Fusarium sp. and Clavibacter michiganensis subsp. michiganensis. Crop Protec. 22: 39-44.
Gaetán SA, Madia de Chaluat MS, Reyna S (1999) Marchitez y podredumbre de la corona y de las raíces del coriandro causado por tres especies de Fusarium en Argentina. Fitopatología 34: 155-159.
Garibaldi A, Gilardi G, Gullino ML (2010) First Report of collar and root rot caused by Pythium ultimum on coriander in Italy. Plant Dis. 94: 1167.
Granados EC, Pérez PR, Soto HM, Ruiz VJ, Lagunez RL, Alonso HN, Gato AR (2014) Inhibition of the growth and development of mosquito larvae of Culex quinquefasciatus (Diptera: Culicidae) treated with extract from leaves of Pseudocalymma alliaceum (Bignonaceae). As- Pac. J. Trop. Med. 7: 594-601.
Guevara Y, Maselli A (2005) Bac-teriosis en cilantro (Coriandrum sativum L.) causada por Xantho-monas campestris (Pammel) Dowson en Venezuela. Rev. Mex. Fitopat. 23: 97-100.
Kim J, Sun MS, Sang GL, Sang CS, Andil KP (2008) Nematicidal activity of plant essential oils and components from coriander (Coriandrum sativum), Oriental sweetgum (Liquidambar orientalis), and valerian (Valeriana wallichii) essential oils against pine wood nematode (Bursa-phelenchus xylophilus). J. Agric. Food Chem. 56: 7316-7320.
Koike ST, Gordon TR (2005) First report of Fusarium wilt of cilantro caused by Fusarium oxysporumin California. Plant Dis. 89: 1130.
Lambert RJW, Skandamis PN, Coote PJ, Nychas GJE (2001) A study of the minimum inhibitory concentration and mode of action of oregano essential oil, thymol and carvacrol. J. Appl. Microbiol. 91: 453-462.
Leslie JF, Summerell BA (2006) TheFusarium Laboratory Manual. Wiley-Blackwell. Ames, IO, EEUU. 388 pp.
Lo Cantore P, Iacobellis NS, De Marco A, Capasso F, Senatore F (2004) Antibacterial activity of Coriandrum sativum L. and Foeniculum vulgare Miller var. vulgare (Miller) essential oils. J. Agric. Food Chem. 52: 7862-7866.
López BA, López BSR, Mendoza ME, Rodríguez HSA, Mendoza EM, Padrón CE (2005) Inhi-bición del crecimiento micelial de Fusarium oxysporum Schle-chtend. f. sp. Lycopersici (sacc.) snyder y hansen, Rhizoctonia solani kühn y Verticilllium dahliae Kleb. mediante extractos vegetales acuosos. Rev. Mex. Fitopatol. 23: 183-190.
McGimpsey JA, Douglas MH, Van KJL, Beauregard DA, Perry NB (1994) Seasonal variation in essential oil yield and composition from naturalized Thymus vulga ris L. in New Zealand. Flav. Frag. J. 9: 347-352.
Mildner SS, Zawirska WR, Obu-chowski W, Gośliński M (2009) Evaluation of antioxidant activity of green tea extract and its effect on the biscuits lipid fraction oxidative stability. J. Food Sci. 74: 362-370.
Msaada K, Hosni K, Taarit MB, Chahed T, Kchouk ME, Marzouk B (2007) Changes on essential oil composition of coriander (Coriandrum sativum L.) fruits during three stages of maturity. Food Chem. 102: 1131-1134.
NCBI (2014) National Center for Biotechnology Information www.ncbi.nlm.nih.gov/ (Cons. 04/2014).
Nelson PE, Toussoun TA, Marasas WFO (1983) Fusarium Species. An Illustrated Manual for Identification. Pennsylvania State University Press. University Park, PA, EEUU. 206 pp.
Ponce AG, Del Valle C, Roura SI (2004) Shelf life of leafy vegetables treated with natural essential oils. J. Food Sci. 69: 50-56.
Prudent D, Perineau F, Bessiere JM, Michel GM, Baccou JC (1995) Analysis of the essential oil of wild oregano from Martinique (Coleus aromaticus Benth.) -evaluation of its bacteriostatic and fungistatic properties. J. Ess. Oil Res. 7: 165-173.
Ranasinghe L, Jayawardena B, Abey wick rama, K (2002) Fungicidal activity of essential oils of Cinnamomum zeylanicum (L.) and Syzygium aromaticum (L.) Merr et L.M. Perry against crown rot and anthracnose pathogens isolated from banana. Lett. Appl. Microbiol. 35: 208-211.
Romeiro RS, Simoes AR, Muchovej JJ, Oliveira JR, Souza RM (1994) Bacterial sudden yellow death and soft rot of Coriandrum sativum. Plant Pathol. 43: 944-946.
Russo M, Galletti GC, Bocchini P, Carnacini A (1998) Essential oil chemical composition of wild populations of Italian oregano spice (Origanum vulgare ssp. hirtum (Link) Ietswaart): A preliminary evaluation of their use in chemotaxonomy by cluster analysis: 1. Inflorescences. J. Agric. Food Chem. 46: 3741-3746.
SAGARPA (2015) Servicio de Infor-mación y Estadística Agro-alimentaria y Pesquera. Secre-taría de Agricultura, Ganadería, Desar rollo Rural, Pesca y Alimentación. México. www. siap.gob.mx/ (Cons. 02/2015).
SAS (2002) The SAS System for Windows. Version 9.1 SAS Institute Inc. Cary, NC, EEUU. Sikkema J, De Bont JAM, Poolman B (1995) Mechanisms of membrane toxicity of hydrocarbons. Microbiol. Rev. 59: 201-222.
Silva F, Ferreira S, Queiroz JA, Domingues FC (2011) Coriander (Coriandrum sativum L.) essential oil: its antibacterial activity and mode of action evaluated by f low cytometry. J. Med. Mi-crobiol 60: 1479-1486.
Sivropoulou A, Papanikolaou E, Nikolaou C, Kokkini S, Lanaras T, Arsenakis M (1996) Antimi-crobial and cytotoxic activities of Origanum essential oils. J. Agric. Food Chem. 44: 1202-1205.
Srivastava US (1972) Effect of interaction of factors on wilt of coriander caused by Fusarium oxysporum Schlecht ex fr. f. corianderii Kulkarni, Nikam & Joshi. Ind. J. Agric. Sci. 42: 618-621.
Thoroski J, Blank G, Biliaderis C (1988) Eugenol induced inhibition of extracellular enzyme production by Bacillus cereus. J. Food Protec. 52: 399-403.
Toben HM, Rudolph K (1996) Pseudomonas syringae pv. coriandricola, incitant of bacterial umbel blight and seed decay of coriander (Coriandrum sativum L.) in Germany. J. Phytopathol. 144: 169-178.
Tripathi P, Shukla AK (2009) Application of essential oils for postharvest control of stem end rot of mango fruits during storage. Int. J. Postharv. Technol. Innov. 1: 405-415.
Verma RK, Chaurasia L, Kumar M (2011) Antifungal activity of essential oils against selected building fungi. Ind. J. Nat. Prod. Resourc. 24: 448-451.
Vincent JM (1947) Distortion of fungal hyphae in the presence of certain inhibitors. Nature 159: 850. Wangensteen H, Samuelsen AB, Malterud KE (2004) Antioxidant activity in extracts from coriander. Food Chem. 88: 293-297.
White TJ, Bruns T, Lee S, Taylor J (1990) Amplification and direct sequencing of fungal ribosomal RNA genes for phylogenetics. En Innis MA, Gelfand DH, Sninsky JJ, White TJ (Eds.) PCR Protocols: A Guide to Methods and Applications. Academic Press. New York, EEUU. pp. 315-321.
Zoubiri S, Baaliouamer A (2010) Essential oil composition of Coriandrum sativum seed cultivated in Algeria as food grains protectant. Food Chem. 122: 1226-1228.
Xiong K, Li XT, Guo S, Li LT, Liu HJ (2014) The antifungal mechanism of electrolyzed oxidizing water against Aspergillus flavus. Food Sci. Biotechnol. 23: 661-669.